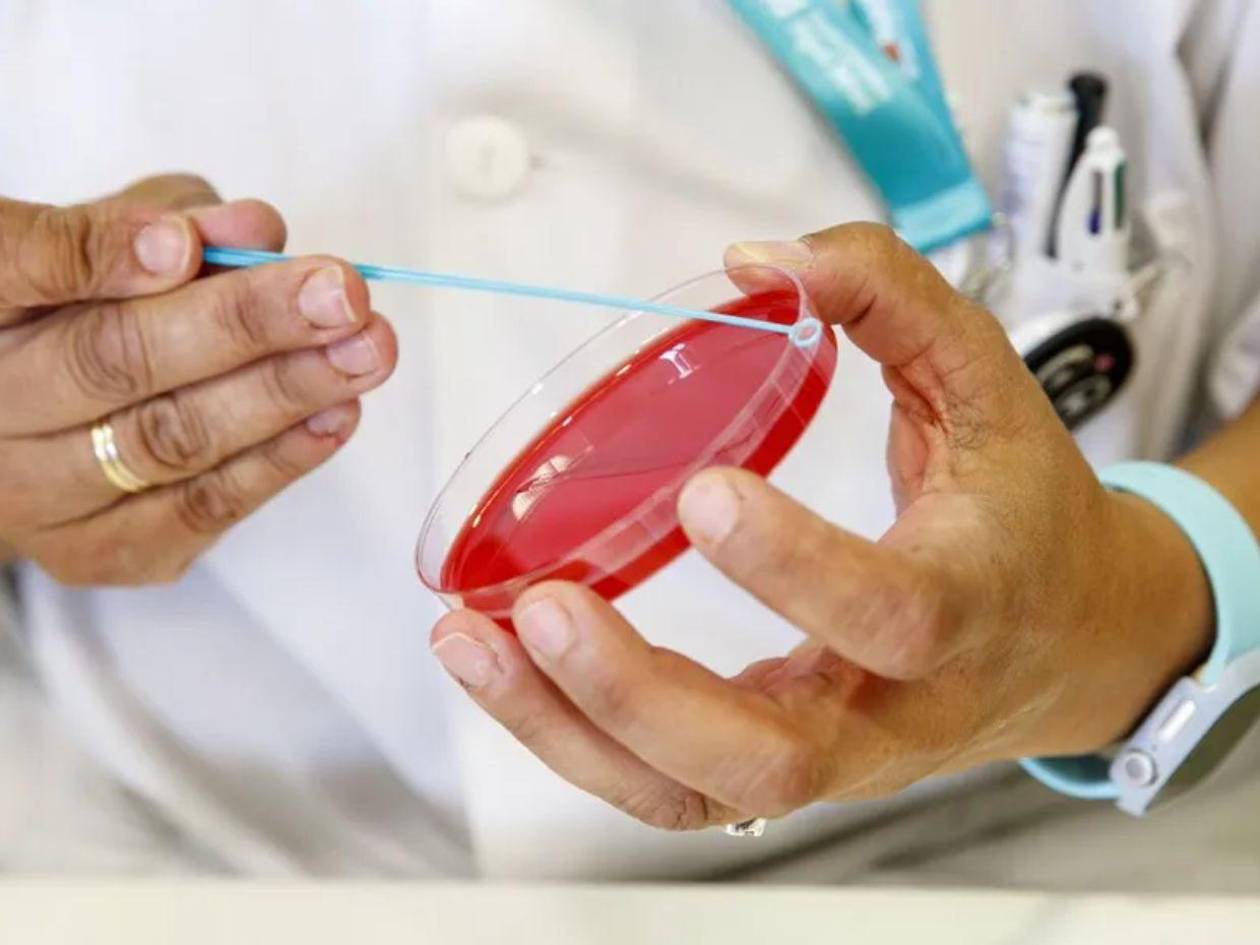

Nueva York, Estados Unidos- Una niña de 8 años que tenía sarampión y no estaba vacunada falleció en Texas (Estados Unidos), lo que supone la segunda muerte por este virus en el estado, donde se han reportado 481 casos desde enero.
La pequeña murió la mañana del jueves en un hospital de la ciudad de Lubbock debido a una insuficiencia pulmonar causada por la enfermedad, según registros médicos a los que ha tenido acceso el periódico The New York Times.
La cadena NBC News, que cita a una fuente familiarizada con el asunto, informa de que el secretario de Salud, el controvertido Robert F. Kennedy Jr.-conocido por sus teorías antivacunas- acudirá hoy al funeral de la fallecida.
El brote de sarampión que azota Estados Unidos desde enero ya se había cobrado la vida de un niño de 8 años en Texas que tampoco estaba vacunado.
Mientras, en Nuevo México un adulto no vacunado que dio positivo en sarampión falleció a principios de marzo, aunque las autoridades no han confirmado la causa exacta de su muerte.
El Departamento Estatal de Servicios de Salud de Texas informó el viernes de que el brote de sarampión que se extiende por las regiones de South Plains y Panhandle ha afectado ya a 481 personas desde finales de enero, de las cuales 56 han sido hospitalizadas.
Del total de pacientes en Texas 471 no estaban vacunados o su estado de vacunación es desconocido, de acuerdo con los datos de este departamento.
Los más afectados por el virus en el estado están siendo los menores de entre 5 y 17 años (180 casos) y los niños de entre 0 y 4 años (157).
Por su parte, en Nuevo México el número total de personas que se han contagiado de sarampión ha ascendido a 54, mientras que en Oklahoma se han registrado ya diez casos.
Estos datos se conocen en un momento en el que crece en Estados Unidos una corriente hasta hace poco minoritaria de personas antivacunas, que se sienten respaldados por Kennedy Jr., si bien este último, tras acceder al cargo, ha atemperado su discurso al respecto.
No obstante, durante el brote de sarampión Kennedy ha defendido tratamientos como el aceite de hígado de bacalao, cuya eficacia no está demostrada.